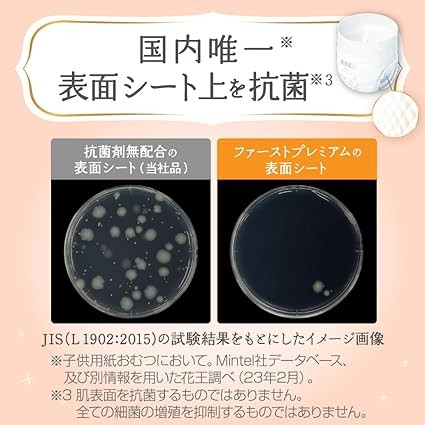

[Pants Big Size] Mary's First Premium (26.5 - 48.5 lbs (12 - 22 kg), 126 Sheets (42 Sheets x 3 Packs) [Case Product] 2x Soft Cashmere Touch [Amazon.co.jp Exclusive]
(0
レビュー)
Estimate Shipping Time:
3 日々
価格:
$31.20
/1
払い戻し:
シェア:
売れ筋商品
![Pants Big Size] Pampers Diapers, Best for Skin (26.6 - 48.5 lbs (12 - 22 kg), 150 Sheets (50 Sheets x 3 Packs) [Case Products] [Amazon.co.jp Exclusive]](https://www.ostrovok-de.com/public/uploads/all/ldDp2vDgLuYGKcvX9lqGq4tvuJgwgjTjhEmDeFE0.jpg)









